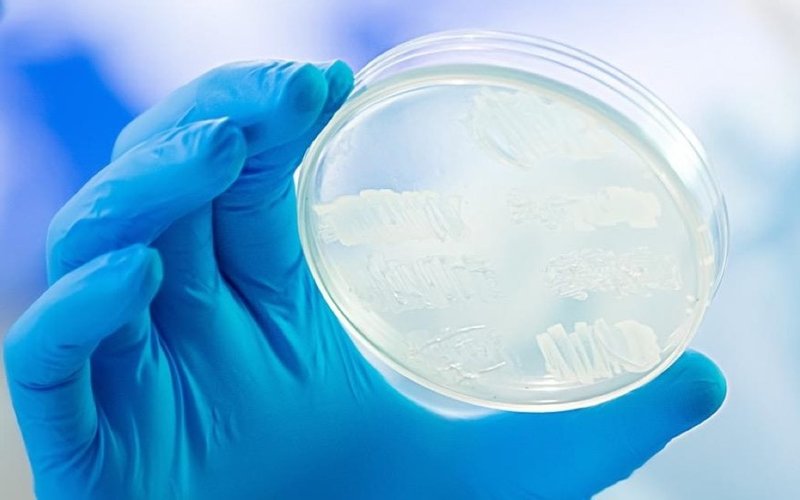
LBT Innovations confirms APAS PharmaQC ready for sale to global biopharma markets

LBT Innovations (ASX: LBT) has announced that its APAS (Automated Plate Assessment System) PharmaQC technology for automated imaging, analysis and interpretation of microbiology culture plates is ready for sale to global markets.
The announcement follows the completion of primary validation testing, the final stage in the commercialisation process with product development partner AstraZeneca.
Testing was completed to pharmacopeial requirements and confirmed APAS PharmaQC as an alternative method of microbiology used in pharmaceutical manufacturing.
Standard practice involves manual reading of the culture plates by microbiologists.
Comprehensive testing
Significant data was generated during the process, with over 35,000 plate images captured, 40,000 plate reads and approximately 3 million colonies counted.
All performance targets for the technology were achieved, including a zero false negative rate and high counting accuracy.
LBT confirmed that no further additional regulatory clearances, licenses or authorities would be required to approve the product.
AstraZeneca is expected to carry out an internal secondary validation of the product within its own manufacturing processes later this year.
Evidence-based automation
Managing director Brent Barnes said APAS PharmaQC supported the need for evidence-based automation in the biopharmaceutical industry.
“The completion of our primary validation is a valuable asset to LBT,” he said.
“We expect this data to build confidence in our technology and assist customers with their adoption of this new product.”
“We have set ourselves an ambitious commercialisation schedule for this year and expect the customer qualification pipeline to accelerate as we present our technology at a number of key global conferences.”
AstraZeneca partnership
In January 2023, LBT partnered with global pharmaceutical firm AstraZeneca on the development of APAS PharmaQC.
The $1m project will see LBT develop the technology for use by AstraZeneca in identifying microbial growth on settle plates used in sterility monitoring during drug manufacturing.
Project costs will be funded by AstraZeneca and LBT will receive payment based on pre-set technical milestones.
Improving data integrity
APAS technology aims to improve data integrity through automation and eliminate issues arising from manual plate reading.
It uses LBT’s state-of-the-art imaging and artificial intelligence algorithms to automatically detect growth on settle plates, creating a digital record and plate image at the time of processing to provide increased traceability of the result.
Once validated, the technology will automatically report negative results, providing improved quality control traceability of results to pharmaceutical laboratories.
Get the wire before the market opens.
The ASX small-cap stories that matter, filed before 9am AEST. Curated by the Small Caps desk.